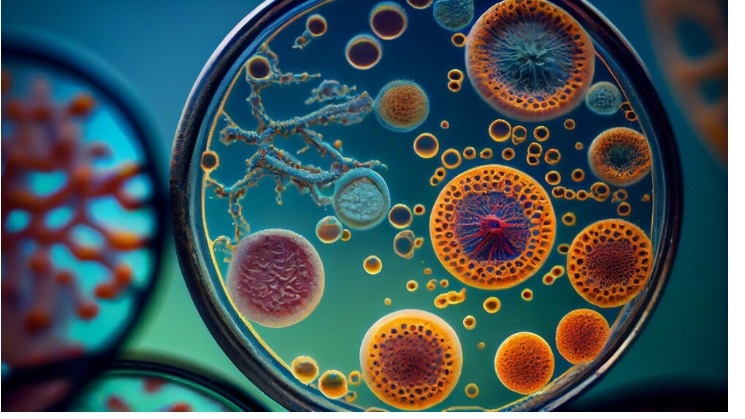

BioTrade Medical supplies LLC
Medical & health support for point of Care centers and
chronic disenses paitents need to be use at home
Medical Supplies LLC is a pioneer company work in field of Medical
import and export for point of care diagnostics supplies Globally also
Point of Care and home health care Medical Products since 2006
Medical supplies in Dubai and Biotina LLC in Sharqah

STANDARD LipidoCare Analyzer
BioTrade Medical supplies LLC
Medical & health support for point of Care centers and
chronic disenses paitents need to be use at home
1 - Pioneering Excellence
Medical Supplies LLC is a pioneer company work in field of Medical
2 - Trusted Since 2006
Point of Care and home health care Medical Products since 2006
3 - Global Reach
import and export for point of care diagnostics supplies Globally also
4 - Regional Presence
Medical supplies in Dubai and Biotina LLC in Sharqah


STANDARD LipidoCare Analyzer
Our Message
Medical & health support for point of Care centers and chronic dispenses patients need to be use at home
Our Target
Point of care centers , Diagnostic labs and home health care Market
Our Goals
Services and support health and Medical Fields
Inquiry Form

BioHermes BH60 Automated Glycohemoglobin Analyzer
Get your medical equipment now and be prepared to care for your health and your loved ones! Don’t wait—quality and precision are in your hands today
Let’s Discuss How We Can Support Your Medical and Health Needs
Our Products
With it, you'll always be at ease: Your precise medical device in every moment
Moments that shaped the Future
Achievements beyond expectations... Moments that shaped the future and turned dreams into reality!


Buckle Tourniquet
Services That
We Provide
With our medical products, we provide you with the trust and quality you need to improve your life. Because your health deserves the best